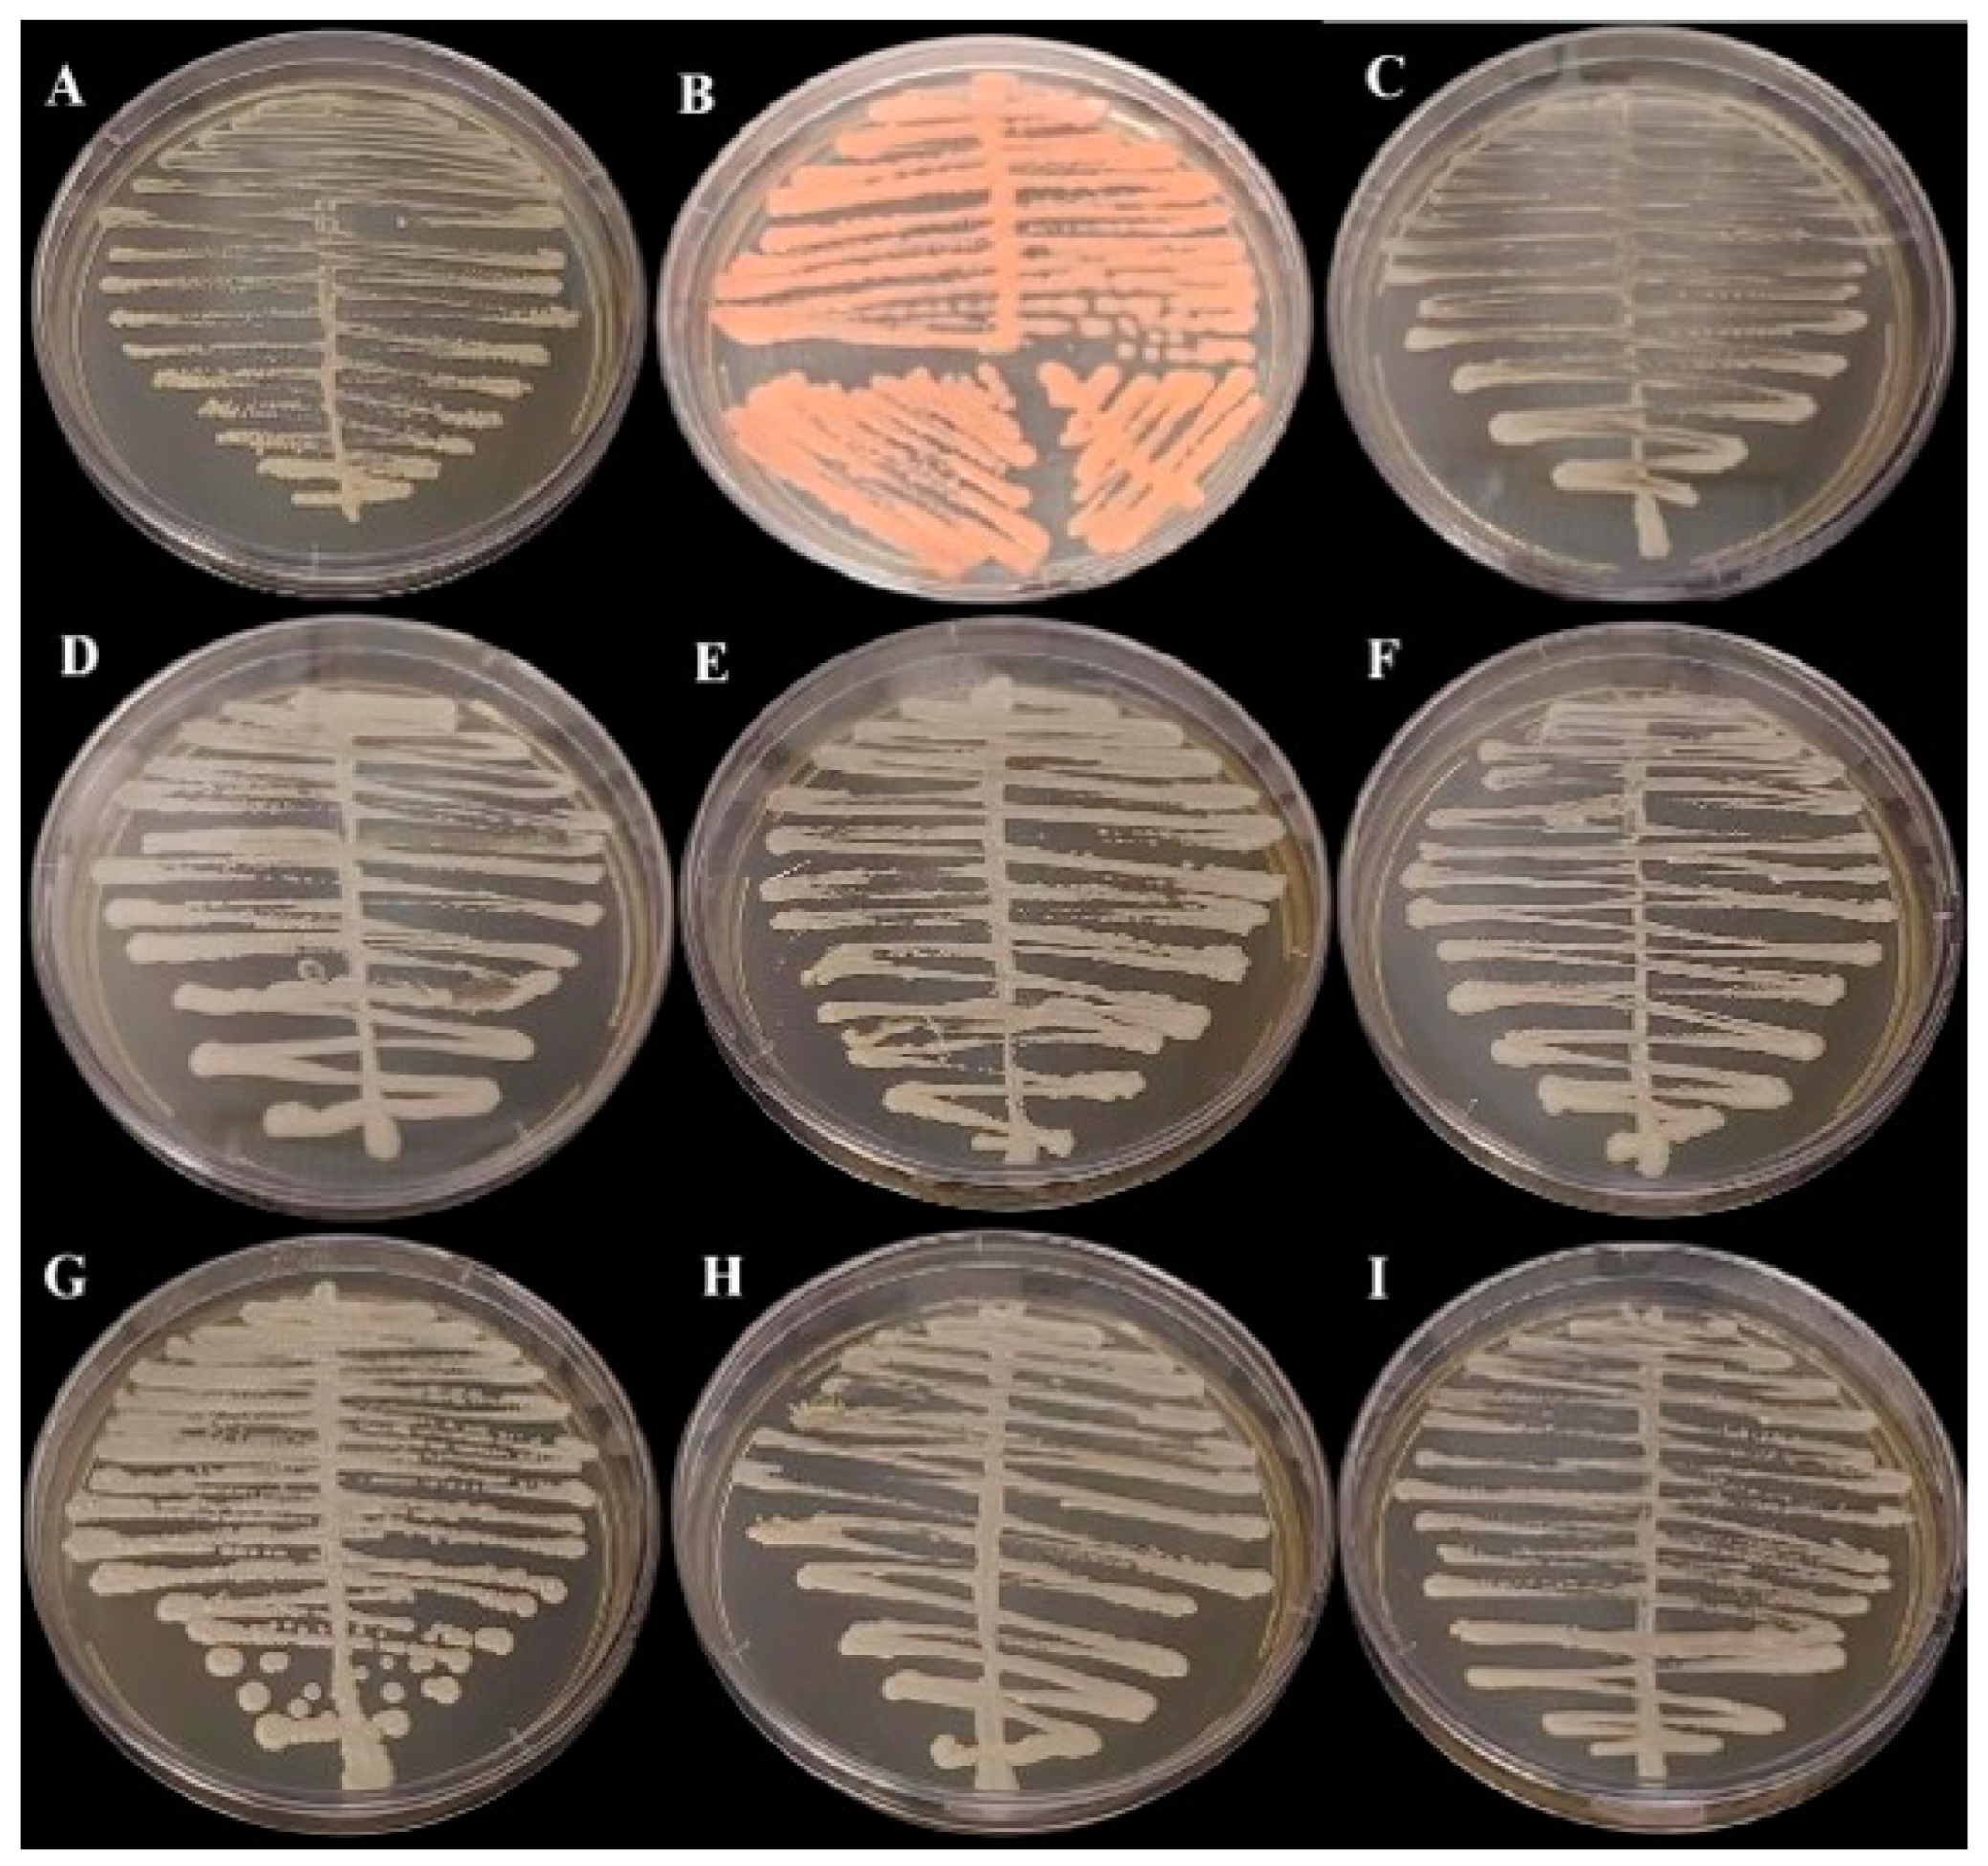
Biomedicines 13 00480 g001 Biomedicines 13 00480 g001

Oral Microbiota and Inflammatory Bowel Diseases: Detection of Emerging Fungal Pathogens and Herpesvirus
Abstract
1. Introduction
2. Materials and Methods
2.1. Sample Collection and Isolation of Yeast
2.2. Phylogenetic Analyses
2.3. Herpesvirus qPCR
2.4. Data Analisis
3. Results
3.1. Characteristics of Patients
3.2. Detection and Characterization of Fungi
3.3. Detection and Characterization of Herpesvirus
4. Discussion
5. Conclusions
Author Contributions
Funding
Institutional Review Board Statement
Informed Consent Statement
Data Availability Statement
Acknowledgments
Conflicts of Interest
Abbreviations
| IBD | Inflammatory Bowel Disease |
| CD | Crohn’s Disease |
| UC | Ulcerative Colitis |
| HPV | Human Papilloma Virus |
| HHV | Human Herpes Virus |
| CMV | Cytomegalovirus |
| EBV | Epstein–Barr virus |
| SDA | Sabouraud Dextrose Agar |
| PCR | Polymerase Chain Reaction |
| qPCR | Real-time PCR |
| EDA | Exploratory Data Analysis |
References
- Alatab, S.; Sepanlou, S.G.; Ikuta, K.; Vahedi, H.; Bisignano, C.; Safiri, S.; Sadeghi, A.; Nixon, M.R.; Abdoli, A.; Abolhassani, H.; et al. The global, regional, and national burden of inflammatory bowel disease in 195 countries and territories, 1990–2017: A systematic analysis for the Global Burden of Disease Study 2017. Lancet Gastroenterol. Hepatol. 2020, 5, 17–30. [Google Scholar] [CrossRef] [PubMed] [PubMed Central]
- Ciorba, M.A.; Konnikova, L.; A Hirota, S.; Lucchetta, E.M.; Turner, J.R.; Slavin, A.; Johnson, K.; Condray, C.D.; Hong, S.; Cressall, B.K.; et al. Challenges in IBD Research 2024: Preclinical Human IBD Mechanisms. Inflam. Bow Dise 2024, 30, S5–S18. [Google Scholar] [CrossRef]
- Pascal, V.; Pozuelo, M.; Borruel, N.; Casellas, F.; Campos, D.; Santiago, A.; Martinez, X.; Varela, E.; Sarrabayrouse, G.; Machiels, K.; et al. A microbial signature for Crohn’s disease. Gut 2017, 66, 813–822. [Google Scholar] [CrossRef] [PubMed] [PubMed Central]
- Hu, S.; Mok, J.; Gowans, M.; Ong, D.E.H.; Hartono, J.L.; Lee, J.W.J. Oral Microbiome of Crohn’s Disease Patients with and Without Oral Manifestations. J. Crohns. Colitis. 2022, 16, 1628–1636. [Google Scholar] [CrossRef] [PubMed] [PubMed Central]
- Deo, P.N.; Deshmukh, R. Oral microbiome: Unveiling the fundamentals. J. Oral Maxillofac. Pathol. 2019, 23, 122–128. [Google Scholar] [CrossRef] [PubMed] [PubMed Central]
- Dewhirst, F.E.; Chen, T.; Izard, J.; Paster, B.J.; Tanner, A.C.R.; Yu, W.-H.; Lakshmanan, A.; Wade, W.G. The human oral microbiome. J. Bacteriol. 2010, 192, 5002–5017. [Google Scholar] [CrossRef] [PubMed] [PubMed Central]
- Martínez, A.; Kuraji, R.; Kapila, Y.L. The human oral virome: Shedding light on the dark matter. Periodontol. 2000 2021, 87, 282–298. [Google Scholar] [CrossRef] [PubMed] [PubMed Central]
- Kumamoto, C.A. Inflammation and gastrointestinal Candida colonization. Curr. Opin. Microbiol. 2011, 14, 386–391. [Google Scholar] [CrossRef] [PubMed] [PubMed Central]
- Ellepola, K.; Truong, T.; Liu, Y.; Lin, Q.; Lim, T.K.; Lee, Y.M.; Cao, T.; Koo, H.; Seneviratne, C.J. Multi-omics analyses reveal synergistic carbohydrate metabolism in Streptococcus mutans-Candida albicans mixed-species biofilms. Infect. Immun. 2019, 87, e00339-19. [Google Scholar] [CrossRef]
- Defta, C.L.; Albu, C.-C.; Albu, Ş.-D.; Bogdan-Andreescu, C.F. Oral Mycobiota: A Narrative Review. Dent. J. 2024, 12, 115. [Google Scholar] [CrossRef] [PubMed] [PubMed Central]
- Rivera, R.E.; Zuluaga, A.; Arango, K.; Kadar, I.; Pinillos, P.A.; Montes, L.F.; Cepeda, E.C.; González, E.; Alfonso, P.A.; Villalba, A.A.; et al. Characterization of oral yeasts isolated from healthy individuals attended in different Colombian dental clinics. J. Biomed. Res. 2019, 33, 333–342. [Google Scholar] [CrossRef]
- D’Enfert, C.; Kaune, A.-K.; Alaban, L.-R.; Chakraborty, S.; Cole, N.; Delavy, M.; Kosmala, D.; Marsaux, B.; Fróis-Martins, R.; Morelli, M.; et al. The impact of the Fungus-Host-Microbiota interplay upon Candida albicans infections: Current knowledge and new perspectives. FEMS Microbiol. Rev. 2021, 45, fuaa060. [Google Scholar] [CrossRef] [PubMed] [PubMed Central]
- Deepa, A.; Nair, B.J.; Sivakumar, T.; Joseph, A.P. Uncommon opportunistic fungal infections of oral cavity: A review. J. Oral Maxillofac. Pathol. 2014, 18, 235–243. [Google Scholar] [CrossRef] [PubMed] [PubMed Central]
- Troska, P.; Sucharzewska, E.; Dynowska, M.; Ejdys, E. Fungi of the genus Rhodotorula isolated from the oral cavity of oncologic patients with colorectal cancer. Ann. Parasitol. 2017, 63, 57–62. [Google Scholar] [CrossRef] [PubMed]
- Chakrabarti, A.; Rudramurthy, S.M.; Kale, P.; Hariprasath, P.; Dhaliwal, M.; Singhi, S.; Rao, K.L.N. Epidemiological study of a large cluster of fungaemia cases due to Kodamaea ohmeri in an Indian tertiary care centre. Clin. Microbiol. Infect. 2014, 20, O83–O89. [Google Scholar] [CrossRef] [PubMed]
- Zhou, M.; Li, Y.; Kudinha, T.; Xu, Y.; Liu, Z. Kodamaea ohmeri as an Emerging Human Pathogen: A Review and Update. Front. Microbiol. 2021, 12, 736582. [Google Scholar] [CrossRef]
- Junqueira, J.C.; Vilela, S.F.G.; Rossoni, R.D.; Barbosa, J.O.; Costa, A.C.B.P.; Rasteiro, V.M.C.; Suleiman, J.M.A.H.; Jorge, A.O.C. Oral colonization by yeasts in HIV-positive patients in Brazil. Rev. Inst. Med. Trop. Sao Paulo. 2012, 54, 17–24. [Google Scholar] [CrossRef] [PubMed]
- Wang, A.; Zhai, Z.; Ding, Y.; Wei, J.; Wei, Z.; Cao, H. The oral-gut microbiome axis in inflammatory bowel disease: From inside to insight. Front. Immunol. 2024, 15, 1430001. [Google Scholar] [CrossRef] [PubMed]
- Underhill, D.M.; Braun, J. Fungal microbiome in inflammatory bowel disease: A critical assessment. J. Clin. Investig. 2022, 132, e155786. [Google Scholar] [CrossRef] [PubMed] [PubMed Central]
- Catalán-Serra, I.; Thorsvik, S.; Beisvag, V.; Bruland, T.; Underhill, D.; Sandvik, A.K.; Granlund, A.v.B. Fungal Microbiota Composition in Inflammatory Bowel Disease Patients: Characterization in Different Phenotypes and Correlation with Clinical Activity and Disease Course. Inflam. Bow Dis. 2024, 30, 1164–1177. [Google Scholar] [CrossRef] [PubMed]
- Yu, M.; Ding, H.; Gong, S.; Luo, Y.; Lin, H.; Mu, Y.; Li, H.; Li, X.; Zhong, M. Fungal dysbiosis facilitates inflammatory bowel disease by enhancing CD4+ T cell glutaminolysis. Front. Cell Infect. Microbiol. 2023, 13, 1140757. [Google Scholar] [CrossRef] [PubMed] [PubMed Central]
- Guzzo, G.L.; Mittinty, M.N.; Llamas, B.; Andrews, J.M.; Weyrich, L.S. Individuals with Inflammatory Bowel Disease Have an Altered Gut Microbiome Composition of Fungi and Protozoa. Microorganisms. 2022, 10, 1910. [Google Scholar] [CrossRef] [PubMed] [PubMed Central]
- El Mouzan, M.; Wang, F.; Al Mofarreh, M.; Menon, R.; Al Barrag, A.; Korolev, K.S.; Al Sarkhy, A.; Al Asmi, M.; Hamed, Y.; Saeed, A.; et al. Fungal Microbiota Profile in Newly Diagnosed Treatment-naïve Children with Crohn’s Disease. J. Crohns Colitis. 2017, 11, 586–592, Erratum in J. Crohns Colitis. 2023, 17, 149. [Google Scholar] [CrossRef] [PubMed]
- Li, Y.; Wang, K.; Zhang, B.; Tu, Q.; Yao, Y.; Cui, B.; Ren, B.; He, J.; Shen, X.; Van Nostrand, J.D.; et al. Salivary mycobiome dysbiosis and its potential impact on bacteriome shifts and host immunity in oral lichen planus. Int. J. Oral Sci. 2019, 11, 13. [Google Scholar] [CrossRef] [PubMed] [PubMed Central]
- Rashed, R.; Valcheva, R.; Dieleman, L.A. Manipulation of Gut Microbiota as a Key Target for Crohn’s Disease. Front. Med. 2022, 9, 887044. [Google Scholar] [CrossRef] [PubMed] [PubMed Central]
- Girija, A.S.S.; Ganesh, P.S. Functional biomes beyond the bacteriome in the oral ecosystem. Jpn. Dent. Sci. Rev. 2022, 58, 217–226. [Google Scholar] [CrossRef] [PubMed] [PubMed Central]
- Xiao, X.; Liu, S.; Deng, H.; Song, Y.; Zhang, L.; Song, Z. Advances in the oral microbiota and rapid detection of oral infectious diseases. Front. Microbiol. 2023, 14, 1121737. [Google Scholar] [CrossRef] [PubMed] [PubMed Central]
- Zhang, H.; Zhao, S.; Cao, Z. Impact of Epstein-Barr virus infection in patients with inflammatory bowel disease. Front. Immunol. 2022, 13, 1001055. [Google Scholar] [CrossRef] [PubMed] [PubMed Central]
- Phadke, V.K.; Friedman-Moraco, R.J.; Quigley, B.C.; Farris, A.B.; Norvell, J.P. Concomitant herpes simplex virus colitis and hepatitis in a man with ulcerative colitis: Case report and review of the literature. Medicine 2016, 95, e5082. [Google Scholar] [CrossRef] [PubMed] [PubMed Central]
- Leal, T.; Arroja, B.; Costa, D.; Ferreira, C.; Soares, J.B.; Gonçalves, R. Colitis due to Cytomegalovirus and Herpes Simplex Type 2 as a Complication of a First Presentation of Inflammatory Bowel Disease. GE Port. J. Gastroenterol. 2021, 29, 56–60. [Google Scholar] [CrossRef] [PubMed] [PubMed Central]
- Altunal, L.; Ozel, A.; Ak, C. Cytomegalovirus reactivation in ulcerative colitis patients: Early indicators. Niger. J. Clin. Pract. 2023, 26, 765–770. [Google Scholar] [CrossRef] [PubMed]
- Pinto, T.N.; Kohn, A.; da Costa, G.L.; Oliveira, L.M.A.; Pinto, T.C.A.; Oliveira, M.M.E. Candida guilliermondii as an agent of postpartum subacute mastitis in Rio de Janeiro, Brazil: Case report. Front. Microbiol. 2022, 13, 964685. [Google Scholar] [CrossRef] [PubMed] [PubMed Central]
- Stevenson, L.G.; Drake, S.K.; Shea, Y.R.; Zelazny, A.M.; Murray, P.R. Evaluation of matrix-assisted laser desorption ionization-time of flight mass spectrometry for identification of clinically important yeast species. J. Clin. Microbiol. 2010, 48, 3482–3486. [Google Scholar] [CrossRef] [PubMed] [PubMed Central]
- Lindsley, M.D.; Hurst, S.F.; Iqbal, N.J.; Morrison, C.J. Rapid identification of dimorphic and yeast-like fungal pathogens using specific DNA probes. J. Clin. Microbiol. 2001, 39, 3505–3511. [Google Scholar] [CrossRef] [PubMed] [PubMed Central]
- Kumar, S.; Stecher, G.; Li, M.; Knyaz, C.; Tamura, K. MEGA X: Molecular Evolutionary Genetics Analysis across Computing Platforms. Mol. Biol. Evol. 2018, 35, 1547–1549. [Google Scholar] [CrossRef] [PubMed] [PubMed Central]
- Saitou, N.; Nei, M. The neighbor-joining method: A new method for reconstructing phylogenetic trees. Mol. Biol. Evol. 1987, 4, 406–425. [Google Scholar] [CrossRef] [PubMed]
- Felsenstein, J. Confidence limits on phylogenies: An approach using the bootstrap. Evolution 1985, 39, 783–791. [Google Scholar] [CrossRef] [PubMed]
- Tamura, K.; Nei, M.; Kumar, S. Prospects for inferring very large phylogenies by using the neighbor-joining method. Proc. Natl. Acad. Sci. USA. 2004, 101, 11030–11035. [Google Scholar] [CrossRef] [PubMed] [PubMed Central]
- Lima, L.R.; Silva, A.P.; Schmidt-Chanasit, J.; Paula, V.S. Diagnosis of human herpes virus 1 and 2 (HHV-1 and HHV-2): Use of a synthetic standard curve for absolute quantification by real time polymerase chain reaction. Mem Inst. Oswaldo. Cruz. 2017, 112, 220–223. [Google Scholar] [CrossRef] [PubMed] [PubMed Central][Green Version]
- Raposo, J.V.; Alves, A.D.R.; Silva, A.d.S.d.; dos Santos, D.C.; Gil Melgaço, J.; Moreira, O.C.; Pinto, M.A.; de Paula, V.S. Multiplex qPCR facilitates identification of betaherpesviruses in patients with acute liver failure of unknown etiology. BMC Infect. Dis. 2019, 19, 773. [Google Scholar] [CrossRef] [PubMed] [PubMed Central]
- Carneiro, V.C.d.S.; Moreira, O.d.C.; Coelho, W.L.d.C.N.P.; Rio, B.C.; Sarmento, D.J.d.S.; Salvio, A.L.; Alves-Leon, S.V.; de Paula, V.S.; Leon, L.A.A. miRNAs in Neurological Manifestation in Patients Co-Infected with SARS-CoV-2 and Herpesvírus 6 (HHV-6). Int. J. Mol. Sci. 2023, 24, 11201. [Google Scholar] [CrossRef] [PubMed]
- Lopes, A.d.O.; Spitz, N.; Martinelli, K.G.; de Paula, A.V.; Toscano, A.L.d.C.C.; Braz-Silva, P.H.; Netto, J.d.S.B.; Tozetto-Mendoza, T.R.; de Paula, V.S. IIntroduction of human gammaherpesvirus 8 genotypes A, B, and C into Brazil from multiple geographic regions. Virus Res. 2020, 276, 197828. [Google Scholar] [CrossRef] [PubMed]
- Fan, Y.-M.; Huang, W.-M.; Yang, Y.-P.; Li, W.; Li, S.-F. Primary cutaneous trichosporonosis caused by Trichosporon dermatis in an immunocompetent man. J. Am. Acad. Dermatol. 2011, 65, 434–436. [Google Scholar] [CrossRef] [PubMed]
- Gunn, S.R.; Reveles, X.T.; Hamlington, J.D.; Sadkowski, L.C.; Johnson-Pais, T.L.; Jorgensen, J.H. Use of DNA sequencing analysis to confirm fungemia due to Trichosporon dermatis in a pediatric patient. J. Clin. Microbiol. 2006, 44, 1175–1177. [Google Scholar] [CrossRef] [PubMed] [PubMed Central][Green Version]
- Montoya, A.M.; Luna-Rodríguez, C.E.; Bonifaz, A.; Treviño-Rangel, R.d.J.; Rojas, O.C.; González, G.M. Physiological characterization and molecular identification of some rare yeast species causing onychomycosis. J. Mycol. Med. 2021, 31, 101121. [Google Scholar] [CrossRef] [PubMed]
- Pagani, D.M.; Heidrich, D.; Paulino, G.V.B.; Alves, K.d.O.; Dalbem, P.T.; de Oliveira, C.F.; Andrade, Z.M.M.; Silva, C.; Correia, M.D.; Scroferneker, M.L.; et al. Susceptibility to antifungal agents and enzymatic activity of Candida haemulonii and Cutaneotrichosporon dermatis isolated from soft corals on the Brazilian reefs. Arch. Microbiol. 2016, 198, 963–971. [Google Scholar] [CrossRef] [PubMed]
- Santo, E.P.T.D.E.; Monteiro, R.C.; da Costa, A.R.F.; Marques-Da-Silva, S.H. Molecular Identification, Genotyping, Phenotyping, and Antifungal Susceptibilities of Medically Important Trichosporon, Apiotrichum, and Cutaneotrichosporon Species. Mycopathologia 2020, 185, 307–317. [Google Scholar] [CrossRef] [PubMed]
- Wade, W.G. The oral microbiome in health and disease. Pharmacol. Res. 2013, 69, 137–143. [Google Scholar] [CrossRef] [PubMed]
- Aggarwal, N.; Kitano, S.; Puah, G.R.Y.; Kittelmann, S.; Hwang, I.Y.; Chang, M.W. Microbiome and Human Health: Current Under-standing, Engineering, and Enabling Technologies. Chem. Rev. 2023, 123, 31–72. [Google Scholar] [CrossRef] [PubMed] [PubMed Central]
- García-Suárez, J.; Gómez-Herruz, P.; Cuadros, J.A.; Burgaleta, C. Epidemiology and outcome of Rhodotorula infection in haematological patients. Mycoses 2011, 54, 318–324. [Google Scholar] [CrossRef] [PubMed]
- Spiliopoulou, A.; Anastassiou, E.D.; Christofidou, M. Rhodotorula fungemia of an intensive care unit patient and review of published cases. Mycopathologia 2012, 174, 301–309. [Google Scholar] [CrossRef] [PubMed]
- Kim, H.A.; Hyun, M.; Ryu, S.-Y. Catheter-associated Rhodotorula mucilaginosa fungemia in an immunocompetent host. Infect. Chemother. 2013, 45, 339–342. [Google Scholar] [CrossRef]
- Pereira, C.; Ribeiro, S.; Lopes, V.; Mendonça, T. Rhodotorula mucilaginosa fungemia and pleural tuberculosis in an immu-nocompetent patient: An uncommon association. Mycopathologia 2016, 181, 145–149. [Google Scholar] [CrossRef] [PubMed]
- Sundararaju, S.; Salah, H.; Ibrahim, E.B.; Perez-Lopez, A.; Ben Abid, F.; Tsui, C.K.M. Draft Genome Sequence of Rhodotorula mucilaginosa from an Adult Patient in Qatar. Microbiol. Resour. Announc. 2021, 10, e0072521. [Google Scholar] [CrossRef] [PubMed] [PubMed Central]
- Jarros, I.C.; Veiga, F.F.; Corrêa, J.L.; Barros, I.L.E.; Gadelha, M.C.; Voidaleski, M.F.; Pieralisi, N.; Pedroso, R.B.; Vicente, V.A.; Negri, M.; et al. Microbiological and virulence aspects of Rhodotorula mucilaginosa. Excli. J. 2020, 19, 687–704. [Google Scholar] [PubMed] [PubMed Central]
- Gao, W.-L.; Liu, T.-T.; Zheng, J.; Hui, F.-L. Kodamaea neixiangensis f.a.; sp. nov. and Kodamaea jinghongensis f.a.; sp. nov.; two yeast species isolated from rotting wood. Int. J. Syst. Evol. Microbiol. 2017, 67, 3358–3362. [Google Scholar] [CrossRef] [PubMed]
- Schoch, C.L.; Ciufo, S.; Domrachev, M.; Hotton, C.L.; Kannan, S.; Khovanskaya, R.; Leipe, D.; Mcveigh, R.; O’neill, K.; Robbertse, B.; et al. NCBI Taxonomy: A comprehensive update on curation, resources and tools. Database 2020, 2020, baaa062. [Google Scholar] [CrossRef] [PubMed] [PubMed Central]
- Wu, J.; Gan, C.; Li, J.; Liu, Y.; Chen, Z.; Zhang, Y.; Yi, G.; Sui, J.; Xu, J. Species Diversity and Antifungal Susceptibilities of Oral Yeasts from Patients with Head and Neck Cancer. Infect. Drug Resist. 2021, 14, 2279–2288. [Google Scholar] [CrossRef] [PubMed] [PubMed Central]
- Stamatiades, G.A.; Ioannou, P.; Petrikkos, G.; Tsioutis, C. Fungal infections in patients with inflammatory bowel disease: A sys-tematic review. Mycoses 2018, 61, 366–376. [Google Scholar] [CrossRef] [PubMed] [PubMed Central]
- Lehman, H.K.; Davé, R. Candida Glabrata Lymphadenitis Following Infliximab Therapy for Inflammatory Bowel Disease in a Patient with Chronic Granulomatous Disease: Case Report and Literature Review. Front. Pediatr. 2021, 9, 707369. [Google Scholar] [CrossRef] [PubMed] [PubMed Central]
- Yoon, H.; Park, S.; Jun, Y.K.; Choi, Y.; Shin, C.M.; Park, Y.S.; Kim, N.; Lee, D.H. Evaluation of Bacterial and Fungal Biomarkers for Dif-ferentiation and Prognosis of Patients with Inflammatory Bowel Disease. Microorganisms 2023, 11, 2882. [Google Scholar] [CrossRef] [PubMed] [PubMed Central]
- Hosomi, S.; Watanabe, K.; Nishida, Y.; Yamagami, H.; Yukawa, T.; Otani, K.; Nagami, Y.; Tanaka, F.; Taira, K.; Kamata, N.; et al. Combined Infection of Human Herpes Viruses: A Risk Factor for Subsequent Colectomy in Ulcerative Colitis. Inflamm. Bowel Dis. 2018, 24, 1307–1315. [Google Scholar] [CrossRef] [PubMed]
- Shimada, T.; Nagata, N.; Okahara, K.; Joya, A.; Hayashida, T.; Oka, S.; Sakurai, T.; Akiyama, J.; Uemura, N.; Gatanaga, H. PCR detection of human herpesviruses in colonic mucosa of individuals with inflammatory bowel disease: Comparison with individuals with immunocompetency and HIV infection. PLoS ONE 2017, 12, e0184699. [Google Scholar] [CrossRef] [PubMed] [PubMed Central]
- Lino, K.; Alves, L.S.; Raposo, J.V.; Medeiros, T.; Souza, C.F.; da Silva, A.A.; de Paula, V.S.; Almeida, J.R. Presence and clinical impact of human herpesvirus-6 infection in patients with moderate to critical coronavirus disease-19. J. Med. Virol. 2022, 94, 1212–1216. [Google Scholar] [CrossRef] [PubMed] [PubMed Central]
- Lino, K.; Alves, L.S.; Trizzotti, N.; Raposo, J.V.; Souza, C.F.; da Silva, A.A.; de Paula, V.S.; Almeida, J.R. Evaluation of herpesvirus members on hospital admission in patients with systemic lupus erythematous shows higher frequency of Epstein-Barr virus and its associ-ated renal dysfunction. J. Bras. Nefrol. 2022, 44, 490–497. [Google Scholar] [CrossRef] [PubMed] [PubMed Central]
- Raposo, J.V.; Sarmento, D.J.D.S.; Pinto, R.B.D.S.; Lopes, A.O.; Gallottini, M.; Tozetto-Mendoza, T.R.; Braz-Silva, P.H.; de Paula, V.S. Longitu-dinal study on oral shedding of human betaherpesviruses 6 and 7 in renal transplant recipients reveals active replication. J. Oral Microbiol. 2020, 12, 1785801. [Google Scholar] [CrossRef] [PubMed] [PubMed Central]
- Guimarães, A.C.S.; Vedovi, J.V.R.; Ribeiro, C.R.d.A.; Martinelli, K.G.; Machado, M.P.; Manso, P.P.d.A.; de Oliveira, B.C.E.P.D.; Bergamini, M.L.; de Rosa, C.S.; Tozetto-Mendoza, T.R.; et al. Cytomegalovirus in Adenoma and Carcinoma Lesions: Detecting Mono-Infection and Co-Infection in Salivary Glands. Int. J. Mol. Sci. 2024, 25, 7502. [Google Scholar] [CrossRef] [PubMed] [PubMed Central]
- Mazaheritehrani, E.; Sala, A.; Orsi, C.F.; Neglia, R.G.; Morace, G.; Blasi, E.; Cermelli, C. Human pathogenic viruses are retained in and released by Candida albicans biofilm in vitro. Virus Res. 2014, 179, 153–160. [Google Scholar] [CrossRef] [PubMed]
- Ascione, C.; Sala, A.; Mazaheri-Tehrani, E.; Paulone, S.; Palmieri, B.; Blasi, E.; Cermelli, C. Herpes simplex virus-1 entrapped in Can-dida albicans biofilm displays decreased sensitivity to antivirals and UVA1 laser treatment. Ann. Clin. Microbiol. Antimicrob. 2017, 16, 72. [Google Scholar] [CrossRef] [PubMed] [PubMed Central]
- Plotkin, B.J.; Sigar, I.M.; Tiwari, V.; Halkyard, S. Herpes Simplex Virus (HSV) Modulation of Staphylococcus aureus and Candida albicans Initiation of HeLa 299 Cell-Associated Biofilm. Curr. Microbiol. 2016, 72, 529–537. [Google Scholar] [CrossRef] [PubMed] [PubMed Central]
- Plotkin, B.J.; Sigar, I.M.; Kaminski, A.; Kreamer, J.; Ito, B.; Kacmar, J. Kinetics of Candida albicans and Staphylococcus aureus Biofilm Initiation on Herpes Simplex Virus (HSV-1 and HSV-2) Infected Cells. Adv. Microbiol. 2020, 10, 583–598. [Google Scholar] [CrossRef]
- Flynn, S.; Eisenstein, S. Inflammatory Bowel Disease Presentation and Diagnosis. Surg. Clin. N. Am. D 2019, 99, 1051–1062. [Google Scholar] [CrossRef] [PubMed]
- Xun, Z.; Zhang, Q.; Xu, T.; Chen, N.; Chen, F. Dysbiosis and Ecotypes of the Salivary Microbiome Associated with Inflammatory Bowel Diseases and the Assistance in Diagnosis of Diseases Using Oral Bacterial Profiles. Front. Microbiol. 2018, 9, 1136. [Google Scholar] [CrossRef] [PubMed] [PubMed Central]

| Isolate | Sex | Age | Type of IBD | Species of Fungi |
|---|---|---|---|---|
| LS01-2 | Male | 51 | UC | Cutaneotrichosporon dermatis |
| LS03-1 | Female | 49 | CD | Rhodotorula mucilaginosa |
| LE07 | Female | 63 | UC | Candida glabrata |
| LS11-1/LS11-2 | Male | 40 | CD | Candida orthopsilosis/Kodamaea jinghongensis |
| LS 13 | Male | 31 | UC | Candida lusitanea |
| LE17-1/LS17-3 | Female | 21 | CD | Kodamaea jinghongensis/Candida orthopsilosis |
| ME20 | Female | 32 | UC | Candida tropicalis |
| Sample | IBD | Viral Load | Fungi Detection | ||
|---|---|---|---|---|---|
| HSV-1 | EBV | HHV-7 | |||
| LS13 | UC | 1.07 × 104 | Undetermined | Undetermined | C. lusitaniae |
| ME20 | UC | Undetermined | 7.40 × 104 | 2.26 × 105 | C. tropicalis |
Disclaimer/Publisher’s Note: The statements, opinions and data contained in all publications are solely those of the individual author(s) and contributor(s) and not of MDPI and/or the editor(s). MDPI and/or the editor(s) disclaim responsibility for any injury to people or property resulting from any ideas, methods, instructions or products referred to in the content. |
© 2025 by the authors. Licensee MDPI, Basel, Switzerland. This article is an open access article distributed under the terms and conditions of the Creative Commons Attribution (CC BY) license (https://creativecommons.org/licenses/by/4.0/).
Share and Cite
Oliveira, M.M.E.; Campos, L.B.; Brito, F.; de Carvalho, F.M.; Silva-Junior, G.O.; da Costa, G.L.; Pinto, T.N.; de Sousa, R.M.P.; Miranda, R.; Castro, R.; et al. Oral Microbiota and Inflammatory Bowel Diseases: Detection of Emerging Fungal Pathogens and Herpesvirus. Biomedicines 2025, 13, 480. https://doi.org/10.3390/biomedicines13020480
Oliveira MME, Campos LB, Brito F, de Carvalho FM, Silva-Junior GO, da Costa GL, Pinto TN, de Sousa RMP, Miranda R, Castro R, et al. Oral Microbiota and Inflammatory Bowel Diseases: Detection of Emerging Fungal Pathogens and Herpesvirus. Biomedicines. 2025; 13(2):480. https://doi.org/10.3390/biomedicines13020480
Chicago/Turabian StyleOliveira, Manoel Marques Evangelista, Letícia Bomfim Campos, Fernanda Brito, Flavia Martinez de Carvalho, Geraldo Oliveira Silva-Junior, Gisela Lara da Costa, Tatiane Nobre Pinto, Rafaela Moraes Pereira de Sousa, Rodrigo Miranda, Rodolfo Castro, and et al. 2025. "Oral Microbiota and Inflammatory Bowel Diseases: Detection of Emerging Fungal Pathogens and Herpesvirus" Biomedicines 13, no. 2: 480. https://doi.org/10.3390/biomedicines13020480
APA StyleOliveira, M. M. E., Campos, L. B., Brito, F., de Carvalho, F. M., Silva-Junior, G. O., da Costa, G. L., Pinto, T. N., de Sousa, R. M. P., Miranda, R., Castro, R., Zaltman, C., & de Paula, V. S. (2025). Oral Microbiota and Inflammatory Bowel Diseases: Detection of Emerging Fungal Pathogens and Herpesvirus. Biomedicines, 13(2), 480. https://doi.org/10.3390/biomedicines13020480

